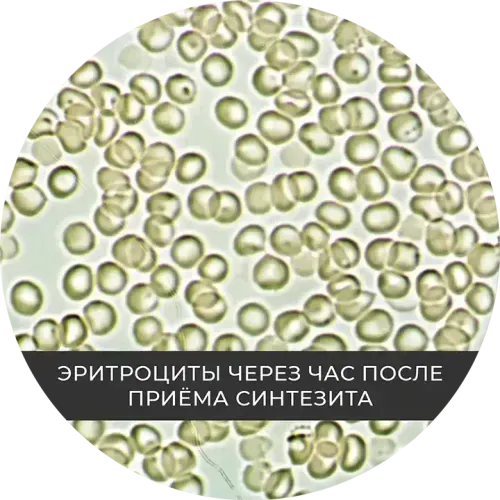
सिंथेसिट लेने के एक घंटे बाद लाल रक्त कोशिकाएं

स्टेम सेल्स — पुनर्जनन के वास्तुकार
स्टेम सेल शरीर की अद्वितीय कोशिकाएँ हैं, जिनमें स्वयं-प्रजनन और ऊतक व अंगों की पुनर्स्थापना के लिए आवश्यक विभिन्न प्रकार की कोशिकाओं में विभेदित (रूपांतरित) होने की क्षमता होती है।

सूक्ष्मदर्शी अनुसंधान
प्रयोगशाला परिस्थितियों में स्टेम सेल का दृश्यांकन

वैज्ञानिक अनुसंधान
स्टेम सेल्स की पुनर्जनन क्षमता का अध्ययन

पुनर्जनन चिकित्सा
आधुनिक चिकित्सा में स्टेम सेल्स का अनुप्रयोग
स्व-नवीकरण
असीमित विभाजन और जनसंख्या रखरखाव की क्षमता
विभेदीकरण
विभिन्न ऊतकों की विशेष कोशिकाओं में रूपांतरण
प्लास्टिसिटी
शरीर की पुनर्स्थापना आवश्यकताओं के अनुकूलन
पुनर्जनन
क्षतिग्रस्त ऊतकों और अंगों की बहाली
स्टेम सेल की उच्चसंख्या होने के लाभ
वैज्ञानिक अनुसंधान दिखाते हैं कि किसी व्यक्ति के अपने स्टेम सेल की मात्रा और गुणवत्ता सीधे मानव स्वास्थ्य और दीर्घायु को प्रभावित करती है।
ऊतक पुनर्प्राप्ति में सुधार
उच्च स्टेम सेल स्तर घाव भरने की गति, चोटों के बाद मांसपेशियों की पुनर्प्राप्ति और विषैले नुकसान से यकृत की पुनर्जनन क्षमता बढ़ाता है।
उम्र बढ़ना से संबंधित परिवर्तनों को धीमा करना
आयु बढ़ने के साथ, स्टेम सेल का प्राकृतिक भंडार कम हो जाता है। उनके उच्च स्तर को बनाए रखना बुढ़ापे के नैदानिक लक्षणों को धीमा कर देता है।
रोगों के जोखिम में कमी
पर्याप्त मात्रा में स्टेम सेल की उपलब्धता हृदय रोग, तंत्रिका क्षय रोग और मांसपेशी-हड्डी संबंधी रोगों के जोखिम को कम करती है।
प्रभावी तनाव प्रतिक्रिया
संक्रमण और सूजन के दौरान, शरीर को पुनर्प्राप्ति के लिए जल्दी से स्टेम सेल भंडार को सक्रिय करने की आवश्यकता होती है।
अध्ययन दिखाते हैं कि उच्च स्टेम सेल स्तर होने पर हृदय रोग संबंधी घटनाओं के जोखिम में 69% कमी होती है
प्रमुख वैज्ञानिक अनुसंधान
स्वास्थ्य और शरीर पुनर्जनन में स्टेम सेल्स की भूमिका को प्रमाणित करने वाले प्रमुख वैज्ञानिक शोधों का संक्षिप्त विवरण
परिसंचारी एंडोथीलियल प्रोजेनिटर कोशिकाएँ
ईपीसी स्तर संवहनी प्रतिक्रियाशीलता और हृदय रोग के जोखिम से संबंधित होता है।
दीर्घकालिक पर्यवेक्षण
उच्च ईपीसी स्तर हृदय संबंधी घटनाओं और मृत्यु दर के जोखिम को कम करता है।
हेटेरोक्रोनिक पराबायोसिस
युवा जीवों से प्राप्त तत्व स्टेम कोशिकाओं की पुनर्जनन क्षमता को पुनर्स्थापित करते हैं।
न्यूरोजेनेसिस और प्लास्टिसिटी
युवा प्लाज़्मा वृद्ध चूहों में न्यूरोजेनेसिस और सिनेप्टिक प्लास्टिसिटी को बेहतर बनाता है।
उद्धरण
10,000 से अधिक वैज्ञानिक शोध इन प्रमुख अध्ययनों का उल्लेख करते हैं
प्रकाशनों
विश्वभर की प्रमुख वैज्ञानिक पत्रिकाओं में प्रकाशित परिणाम
अनुसंधान
दुनिया भर में 100 से ज़्यादा क्लिनिकल स्टडीज़ की गई हैं
स्टेम सेल कीसंख्या क्योंघटती है?
शरीर में स्टेम सेल की संख्या और गुणवत्ता विभिन्न कारकों के प्रभाव में धीरे-धीरे कम हो जाती है, जिससे पुनर्जनन और पुनर्प्राप्ति की प्रक्रियाएँ धीमी हो जाती हैं।
उम्र बढ़ने से संबंधित परिवर्तन
बुढ़ापे के साथ, स्टेम सेल की मात्रा और गुणवत्ता स्वाभाविक रूप से कम हो जाती है, जिससे पुनर्जनन की प्रक्रियाएँ धीमी हो जाती हैं।
40%
की गिरावट 60 वर्ष की आयु तक हो जाती है
आनुवंशिक कारक
वंशानुगत लक्षण स्टेम सेल पूल के क्षय की गति और उनकी स्वयं-नवीनीकरण क्षमता को प्रभावित कर सकते हैं।
25%
आनुवंशिक प्रभाव
ऑक्सीडेटिव स्ट्रेस्स
फ्री रेडिकल और ऑक्सीडेटिव तनाव स्टेम सेल के DNA को नुकसान पहुंचाते हैं, जिससे उनकी जीवित रहने की क्षमता कम हो जाती है।
35%
कोशिका क्षति
जीवन शैली
धूम्रपान, शराब, खराब आहार और शारीरिक गतिविधि की कमी स्टेम सेल की कमी को तेज करती है।
30%
नकारात्मक प्रभाव
दीर्घकालिक तनाव
दीर्घकालिक तनाव स्टेम सेल भंडार की कमी और उनकी पुनर्जनन क्षमता में कमी का कारण बनता है।
दीर्घकालिक रोग
विभिन्न रोगात्मक स्थितियाँ स्टेम सेल पूल के क्षय को तेज़ कर सकती हैं और उनके कार्यों में बाधा डाल सकती हैं।
स्टेम सेल की संख्या में गिरावट 25 वर्ष की उम्र से ही शुरू हो जाती है और उम्र बढ़ने के साथ यह तेज़ हो जाती है।
पारंपरिक स्टेम सेल थेरेपी विधियों की लागत
पारंपरिक स्टेम सेल उपचार विधियाँ, प्रभावी होने के बावजूद, उच्च लागत के कारण अक्सर सुलभ नहीं होतीं।
ऑर्थोपेडिक इंजेक्शन
$5,156
$1,150 - $12,000
घुटने के ऑस्टियोआर्थराइटिस और अन्य जोड़ों की बीमारियों का उपचार
इंट्रावेनस इन्फ्यूज़न
$25,000
$10,000 - $50,000
सिस्टमिक थेरेपी के लिए मेसेंकाइमल स्टेम सेल
आंटी-एजिंग थेरापी
$16,500
प्रति प्रक्रिया
कायाकल्प और ऊतक पुनर्जनन के लिए इंजेक्शन
स्टेम सेल मार्किट
वैश्विक स्टेम सेल थेरेपी मार्किट की कीमत कई अरब डॉलर है और यह लगातार बढ़ रहा है। हालांकि, उच्च लागत के कारण यह अधिकांश मरीजों के लिए सुलभ नहीं है।
25+
अरब डॉलर
15%
प्रति वर्ष वृद्धि
सीमित उपलब्धता
अधिकांश प्रक्रियाओं को बीमा कंपनियों द्वारा कवर नहीं किया जाता है और इसके लिए महत्वपूर्ण व्यक्तिगत खर्च की आवश्यकता होती है।
उच्च जोखिम
लागत के अलावा, इन प्रक्रियाओं में अक्सर लंबी पुनर्वास अवधि की आवश्यकता होती है और इनके कुछ दुष्प्रभाव भी हो सकते हैं।
पुनर्जनन और दीर्घायु की कुंजी
स्टेम सेल शरीर की अद्वितीय कोशिकाएँ होती हैं, जो स्वयं को पुनः उत्पन्न करने और विभिन्न प्रकार की विशिष्ट कोशिकाओं में परिवर्तित होने में सक्षम होती हैं। ये ऊतक मरम्मत, घाव भरने और जीवन भर शरीर के स्वास्थ्य को बनाए रखने में महत्वपूर्ण भूमिका निभाती हैं।

ऊतक पुनर्जनन
स्टेम सेल्स में स्वयं को पुनः उत्पन्न करने और विभिन्न प्रकार की विशिष्ट कोशिकाओं में परिवर्तित होने की अद्वितीय क्षमता होती है।
अंग पुनर्स्थापना
स्टेम सेल्स की उच्च मात्रा क्षतिग्रस्त अंगों की प्रभावी मरम्मत और पुनरुत्पादन सुनिश्चित करती है।
शरीर का कायाकल्प
सक्रिय स्टेम सेल्स उम्र बढ़ने की प्रक्रियाओं को धीमा करती हैं और कोशिका स्तर पर स्वास्थ्य बनाए रखती हैं।
बीमारी से सुरक्षा
पर्याप्त स्टेम सेल्स विभिन्न बीमारियों के जोखिम को कम करते हैं और प्रतिरक्षा प्रणाली को मजबूत बनाते हैं।
सिंथेसिट: स्टेम सेल सक्रियण में एक क्रांतिकारी बदलाव
सिंथेसिट एक नवाचारपूर्ण खनिज है जो शरीर की अपनी स्टेम सेल्स के उत्पादन को उत्तेजित करता है, उनकी संख्या को 2.5 गुना तक बढ़ाता है और उनकी कार्यात्मक क्षमता में सुधार करता है।
वैज्ञानिक खोजें
अनुसंधान से पता चलता है कि स्टेम सेल्स की संख्या और मानव स्वास्थ्य के बीच सीधा संबंध होता है।
नैदानिक परिणाम
स्टेम सेल्स का उच्च स्तर हृदय रोग के जोखिम को 69% तक कम करता है।
वैज्ञानिक रूप से सिद्ध प्रभावशीलता
नैदानिक अनुसंधान
अध्ययन दर्शाते हैं कि सिंथेसिट का नियमित सेवन शरीर में स्टेम सेल्स की संख्या को उल्लेखनीय रूप से बढ़ाता है।
कार्रवाई की प्रणाली
सिंथेसिट शरीर की प्राकृतिक पुनरुत्पादन प्रणालियों को सक्रिय करता है और अस्थि मज्जा द्वारा स्वयं की स्टेम सेल्स के उत्पादन को उत्तेजित करता है।
दीर्घकालिक परिणाम
सिंथेसिट का दीर्घकालिक उपयोग समग्र स्वास्थ्य में सुधार करता है और शरीर की उम्र बढ़ने की प्रक्रियाओं को धीमा करता है।

2.5 गुना
अधिक स्टेम सेल्स
उपलब्धियां और पहचान
सिंथेसिट को विश्वभर के वैज्ञानिक समुदाय, एथलीट और आम लोगों से मान्यता प्राप्त है

सिंथेसिट के बारे में
सिंथेसिट एक अभिनव सप्लीमेंट है, जिसे प्रमुख रूसी वैज्ञानिकों ने रक्त परिसंचरण और ऊतकों में ऑक्सीजन की आपूर्ति को बेहतर बनाने के लिए विकसित किया है।
रक्त की रियोलॉजी में सुधार करता है
जुड़ी हुई लाल रक्त कोशिकाओं को अलग करता है, सूक्ष्म परिसंचरण और ऊतकों तक ऑक्सीजन की आपूर्ति में सुधार होता है।
हृदय की कार्यप्रणाली को सामान्य बनाता है
रक्त की तरलता और ऑक्सीजन संतृप्ति में सुधार करके हृदय की मांसपेशियों पर भार कम करता है।
मस्तिष्क की गतिविधि को सक्रिय करता है
मस्तिष्क में रक्त आपूर्ति में सुधार करके एकाग्रता और संज्ञानात्मक कार्यों को बढ़ाता है।
वैज्ञानिक रूप से सिद्ध प्रभाव
प्रमुख चिकित्सा केंद्रों में अनेक नैदानिक अध्ययनों द्वारा प्रभावशीलता की पुष्टि की गई है।

सिंथेसिट रक्त को पतला करता है और जुड़ी हुई लाल रक्त कोशिकाओं को अलग करता है
यह प्रभाव अद्वितीय है और इसे विभिन्न व्यक्तियों के रक्त नमूनों पर प्रयोगशाला स्थितियों में सिद्ध किया गया है, जिनकी जाँच मिनरल सिंथेसिट लेने से पहले और एक घंटे बाद की गई थी।

लाल रक्त कोशिकाएँ (एरिथ्रोसाइट्स) सबसे अधिक संख्या में पाए जाने वाले रक्त कोशिकाएं हैं, जिनमें हीमोग्लोबिन होता है। इनका मुख्य कार्य ऊतकों और अंगों तक ऑक्सीजन पहुँचाना है।
अंगों और ऊतकों का अपर्याप्त पोषण रोगों का कारण बन सकता है
सिंथेसिट द्वारा लाल रक्त कोशिकाओं का पृथक्करण शरीर में स्वयं की स्टेम कोशिकाओं के उत्पादन को बढ़ावा देता है
विशेषज्ञों की राय
पुनर्योजी चिकित्सा के अग्रणी विशेषज्ञ सिंथेसिट के स्टेम सेल की संख्या पर प्रभाव को लेकर अपने अनुभव साझा करते हैं।

ओइनोटकिनोवा ओल्गा शोनकोरोव्ना
पीएचडी, प्रोफेसर
ओल्गा शोंकोरोव्ना ने द्वितीय वैज्ञानिक-व्यावहारिक सम्मेलन में सिंथेसिट पर एक विस्तृत रिपोर्ट प्रस्तुत की। उन्होंने कीमोथेरेपी से गुजर रहे मरीजों पर इस खनिज के प्रभाव से संबंधित कई अध्ययनों की निगरानी भी की।
सिंथेसिट के सिद्ध गुण
2019 से कई रूसी और अंतर्राष्ट्रीय संस्थानों में किए गए वैज्ञानिक अनुसंधानों के परिणामस्वरूप, हमें सिंथेसिट के पूरे शरीर, एंजाइम, कोशिकीय संरचनाओं और यहां तक कि मानव जीनोम पर शक्तिशाली प्रभाव के ठोस वैज्ञानिक प्रमाण प्राप्त हुए हैं।
ऊर्जा में वृद्धि
मस्तिष्क की माइटोकॉन्ड्रिया में ATP संश्लेषण 35% बढ़ता है, और मांसपेशियों में 60% तक बढ़ता है।
रक्त में ऑक्सीजन की आपूर्ति
MCH में 10% की वृद्धि होती है, और रक्त में ऑक्सीजन संतृप्ति 100% तक पहुँच जाती है।

यह अस्थि मज्जा के कार्य में सुधार करता है।
अस्थि मज्जा द्वारा उत्पन्न स्टेम कोशिकाओं की संख्या 2.5 गुना बढ़ जाती है

रक्त मानकों का सामान्यीकरण
रक्त की तरलता में सुधार करता है, ALT और AST स्तरों को सामान्य करने में मदद करता है और कोलेस्ट्रॉल को 40% तक कम करता है
लोग सिंथेसिट के बारे में क्या कहते हैं
वास्तविक लोगों की समीक्षाएँ जिन्होंने अपने अनुभव के आधार पर सिंथेसिट की प्रभावशीलता को परखा है।
"मेरे पति ने सिंथेसिट लेना शुरू किया और उनका पेट दर्द बंद हो गया, ताकत बढ़ी और शरीर में कई अच्छे बदलाव आए"
युलिया बी.
ग्राहक

अक्सर पूछे जाने वाले प्रश्न
सिंथेसिट के बारे में सबसे आम प्रश्नों के उत्तर
स्वस्थ दीर्घायु के बारे में और जानें
हमारे कम्युनिकेशन चैनलों को सब्सक्राइब करें ताकि आपको स्टेम सेल्स और जीवन की गुणवत्ता बेहतर बनाने के आसान तरीकों की ताज़ा जानकारी मिलती रहे — बिना किसी अनावश्यक खर्च के।
आपको क्या मिलेगा?
सिंथेसिट और हमारे स्वास्थ्य पर इसके प्रभाव से जुड़ा वैज्ञानिक शोध
दुनिया भर के लोगों के अनुभव और कहानियाँ जो पहले से ही सिंथेसिट का इस्तेमाल कर रहे हैं
बिना ज़्यादा खर्च किए स्वस्थ जीवनशैली के लिए सुझाव
विशेष सामग्री तक पहुंच
नियमित अपडेट
हम नियमित रूप से नई सामग्री प्रकाशित करते हैं ताकि आप स्वस्थ दीर्घायु से जुड़ी नवीनतम उपलब्धियों से अपडेट रहें।
विशेषज्ञ की राय
सभी सामग्री चिकित्सा, विज्ञान और तकनीक के विशेषज्ञों के सहयोग से तैयार की जाती है।
CONTACTS
Disclaimer:
Synthesit products are not intended to diagnose, treat, cure, or prevent any disease. Results may vary for each customer. The information presented does not constitute medical advice and it should not be relied upon as such. Consult your doctor before modifying your regular medical regime.


